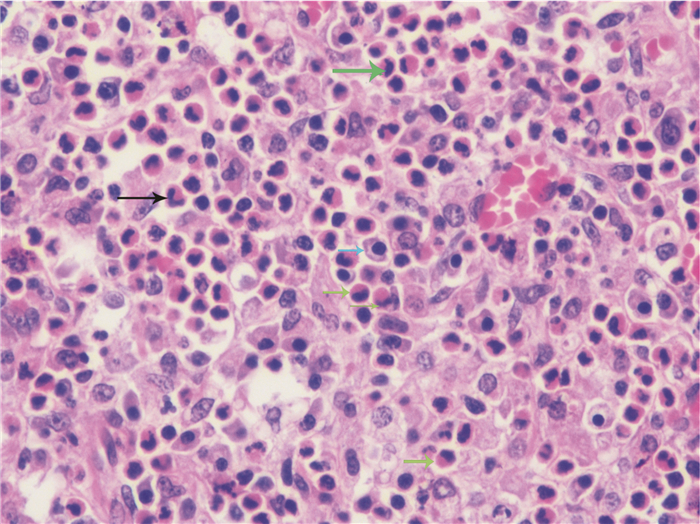

2004~2014年,我国突发公共卫生事件管理信息系统共报告蘑菇中毒事件576起,中毒3 701例,死亡786例,病死率21.24%,是造成食源性中毒事件死亡的主要原因之一[1]。陈作红等[2]1994-2012年对102起蘑菇中毒事件调查显示,70.49 %死亡病例是由鹅膏属蘑菇导致,蘑菇中鹅膏肽类毒素引起中毒性肝功能衰竭是死亡的主要原因。致命鹅膏是鹅膏肽类毒素含量最高的蘑菇种类之一,也是引起我国蘑菇中毒死亡的主要种类之一[3]。本研究通过建立比格犬致命鹅膏急性肝毒性模型,观察其中毒性肝功能衰竭特点,以期为含鹅膏肽类毒素蘑菇中毒的诊断和治疗研究提供一定帮助。
1 材料与方法 1.1 致命鹅膏干粉制备100 g致命鹅膏干子实体由湖南师范大学陈作红教授提供,研磨成粉末并充分混匀,梅花形布点各点取致命鹅膏干粉0.2 g,分别测定其中鹅膏肽类毒素(α-鹅膏毒肽、β-鹅膏毒肽、γ-鹅膏毒肽和羧基二羟鬼笔毒肽)含量。梅花形布点法如图 1。

|
| 图 1 梅花形布点法 Figure 1 Plum blossom shaped distribution |
|
|
普通级雄性纯种比格犬[(由北京中科灵瑞生物技术股份有限公司提供,SCXK (京)2015-0011)]6只,8~10月龄,体质量8~10 kg。
1.3 主要仪器和试剂 1.3.1 仪器Waters ACQUITYTM超高效液相色谱仪(Waters公司,美国),Waters XevoTM TQ-S三重四级杆串联质谱仪(Waters公司,美国),HSS T3色谱柱(100 mm×2.1 mm,1.7 μm, Waters公司,美国),HLB固相萃取柱(3 ml,60 mg, Waters公司,美国),M2型血凝分析仪(TECO公司,德国),EPOCH酶标仪(BIOTECH公司,美国),旋涡混旋器(IKA公司,德国),超声波细胞破碎仪(Branson公司,美国),X-22R型低温离心机(Beckman公司,美国),N-EVAPTM-116型氮吹仪(Organomation公司,美国),DS-Fi2正置显微镜(Nikon公司,日本)。
1.3.2 试剂α-鹅膏毒肽、β-鹅膏毒肽、γ-鹅膏毒肽和羧基二羟鬼笔毒肽标准品购于美国Sigma公司,凝血酶原时间(prothrombin,PT)和活化部分凝血活酶时间(activated partial thromboplastin time,APTT)检测试剂盒购于德国TECO公司,谷丙转氨酶(alanine aminotransferase,ALT)、谷草转氨酶(aspartate aminotransferase,AST)、碱性磷酸酶(alkaline phosphatase,ALP)、总胆红素(total bilirubin,TBIL)、尿素氮(blood urea nitrogen,BUN)、血肌酐(creatinine,CRE)检测试剂盒均购于中国南京建成生物工程研究所,乙腈、纯水、甲醇、乙酸铵(HPLC级)购于美国Sigma公司。
1.4 鹅膏肽类毒素的检测 1.4.1 致命鹅膏中鹅膏肽类毒素的提取准确称取0.2 g致命鹅膏干粉于15 mL离心管中,加入10 mL超纯水,漩涡震荡1 min,超声提取30 min后,于4 ℃以10 000 r/min离心10 min,取上清液,用超纯水稀释2倍,供UPLC-MS/MS测定。
1.4.2 血浆中鹅膏肽类毒素的提取吸取0.5 mL血浆于10 mL试管中,加入1.5 mL乙腈,超声20 min,以9 000 r/min离心10 min,取上清液,40 ℃水浴氮气吹干,1 mL超纯水复溶,所得液体通过预先用3 mL甲醇和3 mL水活化的HLB固相萃取柱(3 mL,60 mg),上样完毕后用1 mL 5%甲醇水溶液淋洗小柱,之后用1 mL甲醇洗脱,收集洗脱液,氮气吹至近干,用超纯水定容至1 mL,供UPLC-MS/MS测定。
1.4.3 尿液中鹅膏肽类毒素的提取将收集的尿液离心,准确量取1 mL通过预先用3 mL甲醇和3 mL水活化的HLB固相萃取柱,上样完毕后用1 mL 5%甲醇水溶液淋洗小柱,之后用1 mL甲醇洗脱,收集洗脱液,氮气吹至近干,用超纯水定容至1 mL,供UPLC-MS/MS测定。
1.4.4 液相色谱条件HSS T3色谱柱; 流动相A为2 mmol /L乙酸铵溶液,流动相B为2 mmol/L乙腈溶液;流动相流速:0.3 mL/min;柱温:40 ℃;进样体积:10 μL;洗脱液梯度见表 1。
| 时间(min) | 流速(mL/min) | 流动相A (%) | 流动相B (%) |
| 0.0 | 0.3 | 80 | 20 |
| 5.0 | 0.3 | 60 | 40 |
| 7.5 | 0.3 | 60 | 40 |
| 7.6 | 0.3 | 80 | 20 |
| 10.0 | 0.3 | 80 | 20 |
电喷雾离子化模式:多反应监测模式(MRM),脱溶剂温度:450℃,毛细管电压:3.5 kV。其他质谱参数见表 2。
| 鹅膏肽类毒素 | 保留时间(min) | 监测离子对(m/z) | 锥孔电压(V) | 碰撞能量(eV) |
| α-鹅膏毒肽 | 2.52 | 920.0/259.1* | 40 | 60 |
| 920.0/86.1 | 40 | 90 | ||
| β-鹅膏毒肽 | 2.95 | 919.0/259.1* | 40 | 80 |
| 919.0/86.1 | 40 | 95 | ||
| γ-鹅膏毒肽 | 3.78 | 903.0/86.1* | 40 | 90 |
| 903.0/243.1 | 40 | 65 | ||
| 羧基二羟鬼笔毒肽 | 4.58 | 848.0/157.1* | 40 | 82 |
| 848.0/86.1 | 40 | 106 |
样品中4种毒素浓度在0.1~100 mg/kg范围内,蘑菇、血浆和尿液中4种毒素的线性相关系数分别在0.9971~0.999 8之间。蘑菇中4种毒素的检出限均为0.03 mg/kg,定量检出限均为0.1 mg/kg;血液和尿液中4种毒素的检出限均为0.01 mg/kg,定量检出限均为0.05 mg/kg。
1.5 模型建立染毒前禁食24 h,禁水12 h,60 mg/kg致命鹅膏干粉胶囊喂饲比格犬,染毒后6 h给予常规饲料及饮水,未提供任何治疗。观察比格犬的中毒表现及死亡情况,并在染毒后0、6、12、24、36、48、72、96、168 h从前肢头静脉分别取血2 mL用于凝血功能指标检测,在染毒后0、6、12、24、36、48、72、96、168、336、504 h从前肢头静脉分别取血2 mL用于肝肾功能检测,在染毒后0、6、12、24、36 h从前肢头静脉分别取血2 mL用于血浆中鹅膏肽类毒素检测,使用犬代谢笼收集0~12 h,12~24 h,24~48 h,48~72 h,72~96 h尿液用于尿液中鹅膏肽类毒素检测。
1.6 观察项目 1.6.1 中毒表现及死亡情况在染毒0、6、12、24、36、48、72、96、120、144 h观察并记录有无食欲减退、乏力、呕吐、腹泻、呕血、便血等情况。
1.6.2 凝血及肝肾功能指标检测凝血功能指标包括PT和APTT,肝功能指标包括ALT、AST、ALP和TBIL,肾功能指标包括BUN和CRE。
1.6.3 病理检查动物死后解剖,取肝脏组织置于10%甲醛固定3 d,生理盐水(0.9% NaCl)冲洗30 min,顺梯度乙醇脱水,浸蜡包埋,横切组织2 mm厚,常规苏木精-伊红(HE)染色后中性树脂封片固定。光学显微镜观察肝脏组织形态。
1.6.4 血浆和尿液中鹅膏肽类毒素检测检测不同时间点血浆和尿液中α-鹅膏毒肽、β-鹅膏毒肽和羧基二羟鬼笔毒肽的含量。
1.7 统计学方法计量资料以均数±标准差(x±s)表示。
2 结果 2.1 致命鹅膏中鹅膏肽类毒素含量致命鹅膏中四种鹅膏肽类毒素总含量为(3 482.6±124.94) mg/kg,4种鹅膏肽类毒素含量由高到低依次为α-鹅膏毒肽(1 945.4±91.1) mg/kg、β-鹅膏毒肽(921.6±58.8) mg/kg、羧基二羟鬼笔毒肽(607.2±40.0) mg/kg和γ-鹅膏毒肽(8.3±0.2) mg/kg。见表 3。
| 鹅膏肽类毒素 | 致命鹅膏中毒素浓度(mg/kg) | 均数±标准差(mg/kg) | ||||
| 1 | 2 | 3 | 4 | 5 | ||
| α-鹅膏毒肽 | 1 875.2 | 1 877.4 | 2 096.3 | 1 919.5 | 1 958.8 | 1 945.4±91.1 |
| β-鹅膏毒肽 | 837.3 | 884.1 | 978.5 | 949.4 | 958.5 | 921.6±58.8 |
| γ-鹅膏毒肽 | 8.5 | 8.1 | 8.5 | 8.3 | 8.2 | 8.3±0.2 |
| 羧基二羟鬼笔毒肽 | 660.7 | 551.5 | 597.3 | 621.4 | 605.2 | 607.2±40.0 |
| 合计 | 3 381.7 | 3 321.1 | 3 680.6 | 3 498.6 | 3 530.7 | 3 482.6±124.9 |
染毒12 h内6只比格犬均未出现任何异常表现。染毒后12~24 h,6只模型比格犬均出现呕吐和腹泻,染毒后12~48 h,6只比格犬均出现食欲下降、虚弱和乏力,24~48 h,1只比格犬出现呕血(24~36 h死亡),1只出现便血(36~48 h死亡)。死亡3只,死亡时间为24~72 h之间,存活3只,存活动物染毒后48 h后中毒情况好转,72 h后中毒症状消失。
2.3 凝血及肝肾功能指标检测染毒后24 h,比格犬ALT、AST、TBIL、ALP、PT和APTT水平出现明显升高[ALT (283.2±98.6)卡门氏单位;AST (125.6±77.4)卡门氏单位;TBIL (7.2±5.3) μmol/L;ALP (123.1±57.6) U/L;PT (59.9±117.7) s;APTT (60.3±117.4) s];染毒后36 h,ALT,AST,PT和APTT达到峰值[ALT (283.2±112.9)卡门氏单位;AST (223.9±93.8)卡门氏单位;PT (132.9±152.6) s;APTT (131.4±153.9) s];染毒后48 h,TBIL和ALP值达到峰值[TB (23.3±14.6) μmol/L)];达到峰值后,存活比格犬TBIL、TP和APTT水平在染毒后1周恢复至正常水平,其ALT、AST和ALP水平在染毒后3周恢复至正常水平。试验期间动物BUN和CRE水平正常。具体指标变化见表 4。
| 染毒时间(h) | 动物数(只) | ALT (卡门氏单位) | AST (卡门氏单位) | TBIL (μmol/L) | ALP (U/L) | PT (s) | APTT (s) | BUN (mmol/L) | CRE E (nmol/L) |
| 0 | 6 | 30.4±9.6 | 7.8±1.7 | 2.9±1.6 | 87.4±21.4 | 7.1±0.4 | 11.8±0.7 | 6.0±2.1 | 95.7±18.6 |
| 6 | 6 | 36.0±11.5 | 13.8±7.8 | 2.5±1.0 | 82.4±19.8 | 6.0±0.5 | 11.3±0.1 | 6.8±2.4 | 95.8±19.5 |
| 12 | 6 | 68.6±45.3 | 18.7±12.3 | 1.8±0.3 | 83.8±21.4 | 7.3±0.4 | 11.3±0.1 | 8.9±2.3 | 92.5±15.8 |
| 24 | 6 | 283.2±98.6 | 125.6±77.4 | 7.2±5.3 | 123.1±57.6 | 59.9±117.7 | 60.3±117.4 | 5.2±0.7 | 86.8±14.6 |
| 36 | 5 | 343.9±112.9 | 223.9±93.8 | 17.7±11.6 | 200.8±95.8 | 132.9±152.6 | 131.4±153.9 | 6.7±1.7 | 92.7±11.9 |
| 48 | 4 | 337.6±63.0 | 155.6±23.0 | 23.3±14.6 | 274.5±115.5 | 90.1±140.1 | 86.8±142.1 | 7.3±1.5 | 102.4±22.3 |
| 72 | 3 | 289.4±94.0 | 71.6±46.2 | 9.8±5.7 | 265.4±86.6 | 11.0±3.1 | 12.5±0.7 | 6.2±2.4 | 107.7±21.6 |
| 96 | 3 | 240.4±77.1 | 28.8±13.6 | 3.9±3.4 | 246.3±93.8 | 8.2±1.0 | 11.3±0.1 | 7.1±2.4 | 106.0±17.7 |
| 168 | 3 | 200.9±63.7 | 11.7±3.4 | 1.8±0.4 | 161.3±30.4 | 6.9±0.4 | 11.3±0.1 | 8.5±2.2 | 103.0±14.6 |
| 336 | 3 | 97.5±28.2 | 9.1±0.2 | 2.4±0.1 | 121.7±11.9 | - | - | 9.3±0.8 | 104.2±15.9 |
| 504 | 3 | 34.0±9.6 | 7.4±1.0 | 3.1±1.4 | 73.8±5.6 | - | - | 6.7±1.8 | 109.5±21.2 |
| 注:“-”表示未进行检测 | |||||||||
比格犬死亡后去肝脏病理肉眼观察发现:肝脏质地柔软,体积未发现明显改变,呈黄色或红褐色,各肝叶均可见暗褐色出血点。见图 2。HE染色肝脏病理切片显微镜下显示:弥漫性肝细胞出血性坏死,肝脏正常结构消失,肝小叶范围不清,门静脉扩张,可见大量红细胞和炎性细胞浸润(嗜酸性粒细胞、中性粒细胞和浆细胞)。见图 3和图 4。

|
| 黑色箭头指向出血点 图 2 中毒死亡比格犬肝脏肉眼观察 Figure 2 The liver from the death dog ingested Amanita exitialis |
|
|

|
| 黑色箭头指向门静脉扩张;黄色箭头指向坏死的肝细胞;绿色箭头指向肝细胞出血性坏死区域 图 3 中毒死亡比格犬肝脏HE染色病理切片(HE×100) Figure 3 Representative photomicrographs of HE stained liver sections from a dog that died 36-48 hour after ingestion of Amanita exitialis(HE×100) |
|
|
|
| 黑色箭头指向中性粒细胞;蓝色箭头指向浆细胞;绿色箭头指向嗜酸性粒细胞 图 4 中毒死亡比格犬肝脏HE染色病例切片(HE×400) Figure 4 Representative photomicrographs of HE stained liver section from a dog that died 36-48 hour after ingestion of Amanita exitialis(HE×400) |
|
|
染毒后6 h,比格犬血浆中α-鹅膏毒肽、β-鹅膏毒肽和羧基二羟鬼笔毒肽浓度分别为(13.5±6.5) μg/L、(7.3±3.3) μg/L和(0.6±0.3) μg/L;染毒后12 h,血浆中能检出α-鹅膏毒肽和β-鹅膏毒肽;染毒后24 h,血浆中能检出α-鹅膏毒肽;染毒后36 h,三种鹅膏肽类毒素在血浆中均未检出。见表 5。染毒后0~12 h,比格犬尿液中α-鹅膏毒肽、β-鹅膏毒肽和羧基二羟鬼笔毒肽浓度分别为(353.5±170.5) μg/L、(186.9±104.8) μg/L和(59.5±37.4) μg/L;染毒后72~92 h,尿液中能检出α-鹅膏毒肽和羧基二羟鬼笔毒肽;染毒后92~120 h,三种鹅膏肽类毒素在尿液中均未检出。见表 6。
| 染毒时间(h) | 动物数量(只) | 毒素种类 | ||
| α-鹅膏毒肽 | β-鹅膏毒肽 | 羧基二羟鬼笔毒肽 | ||
| 0 | 6 | - | - | - |
| 6 | 6 | 13.5±6.5 | 7.3±3.3 | 0.6±0.3 |
| 12 | 6 | 0.6±0.4 | 0.3±0.2 | - |
| 24 | 6 | 0.2±0.2 | - | - |
| 36 | 5 | - | - | - |
| 注:“-”表示未检出 | ||||
| 染毒时间(h) | 动物数量(只) | 毒素种类 | ||
| α-鹅膏毒肽 | β-鹅膏毒肽 | 羧基二羟鬼笔毒肽 | ||
| 0~12 | 6 | 353.5±170.5 | 186.9±104.8 | 59.5±37.4 |
| 12~24 | 6 | 49±28.3 | 21.6±13.8 | 41.1±25.3 |
| 24~48 | 5 | 9.1±6.4 | 5.2±4.8 | 27.8±19.7 |
| 48~72 | 4 | 8.7±6.2 | 6.8±5.4 | 4.7±3.6 |
| 72~96 | 3 | 3.2±2.9 | - | 1.2±1.4 |
| 96~120 | 3 | - | - | - |
| 注:“-”表示未检出 | ||||
2004-2011年,我国突发公共卫生事件报告管理信息系统报告显示,鹅膏属蘑菇中毒事件共60起,中毒271例,死亡98例,分别占蘑菇中毒事件总数、中毒例数和死亡例数的61.2 %、57.2 %和64.5 %[4]。鹅膏属蘑菇中主要含有鹅膏毒肽、鬼笔毒肽和毒伞肽,是引起肝功能衰竭的主要毒素[5]。α-鹅膏毒肽对人的致死剂量为0.1 mg/kg[6],本研究所使用致命鹅膏干粉中α-鹅膏毒肽的含量为1 945.4 mg/kg,照此计算,约3 g致命鹅膏干粉可致60 kg体质量的成人死亡。因比格犬为哺乳类动物,含鹅膏肽类毒素蘑菇的中毒表现与人类更接近[7],取血、染毒等实验操作方便,且便于对蘑菇中毒救治方法(如血液净化技术)开展后续评价研究,故本研究选取比格犬建立致命鹅膏中毒模型。
Diaz[8]研究显示,含鹅膏肽类毒素蘑菇中毒潜伏期一般为数小时至数十小时。随后,进入胃肠炎期,首发症状通常为呕吐、腹痛、腹泻等表现,可持续12~24 h,此阶段肝功能检查多无异常[9-10]。随着鹅膏肽类毒素进入肝脏对其造成损害,出现黄疸、肝昏迷、凝血功能障碍、转氨酶迅速升高等表现[11],严重者多在摄入后3~7 d因急性肝功能衰竭而死亡,轻症病例一般在2~3周进入恢复期,实验室检查指标逐渐恢复正常[12]。本研究中,致命鹅膏致比格犬急性肝功能衰竭模型染毒12 h内未出现任何异常表现,12~48 h出现呕吐、腹泻、食欲下降、虚弱和乏力,24~48 h部分动物出现呕血和便血,凝血及肝功能指标出现明显异常,肝脏病理显示弥漫性肝细胞出血性坏死,肝脏正常结构消失,可见大量红细胞和炎性细胞浸润,该模型可体现含鹅膏肽类毒素中毒肝衰竭的临床特点。
鹅膏毒肽可经人和哺乳动物胃肠道吸收,血液中鹅膏毒肽不与蛋白结合,进入肝脏的鹅膏毒肽被排入胆汁,胆汁进入肠道,形成肠肝循环[13]。另外,血液中的鹅膏毒肽可经肾小球滤过和肾小管重吸收,部分经尿液排出[14]。血液中鹅膏毒肽浓度降低非常迅速,一项研究报告,摄入30 h后,65%病例血液中检测出鹅膏毒肽,浓度在0.5~24 ng/mL,而摄入48 h后,所有病例血液中均未检出鹅膏毒肽[15]。尿中鹅膏毒肽浓度要高于血液且存在时间长于血液,Jaeger等[14]研究发现,尿中鹅膏毒肽浓度是血液的10~100倍,部分病例血液未发现鹅膏毒肽,但尿液中仍能检出。本实验模型犬血浆和尿液中鹅膏肽类毒素含量变化结果与文献报道一致,染毒后24 h内,血浆中可检测到鹅膏肽类毒素;染毒后96 h内,尿液中可检测到鹅膏肽类毒素,且尿液中鹅膏肽类毒素浓度明显高于血中。
| [1] |
周静, 袁媛, 郎楠, 等. 中国大陆地区蘑菇中毒事件及危害分析[J].
中华急诊医学杂志 , 2016, 25 (6) : 724-728 Zhou J, Yuan Y, Lang N, et al. Analysis of hazard in mushroom poisoning incidents in China mainland[J]. Chin J Emerg Med , 2016, 25 (6) : 724-728 DOI:10.3760/cma.j.issn.1671-0282.2016.06.008 |
| [2] | Chen ZH, Zhang P, Zhang GZ, et al. Investigation and analysis of 102 mushroom poisoning cases in Southern China from 1994 to 2012[J]. Fungal Diversity , 2014, 64 : 123-131 DOI:10.1007/s13225-013-0260-7 |
| [3] |
孙承业. 蘑菇中毒防治工作亟需加强[J].
中华急诊医学杂志 , 2016, 25 (8) : 981-984 Sun CY. Improvement in mushroom poisoning control is in urgent need[J]. Chin J Emerg Med , 2016, 25 (8) : 981-984 DOI:10.3760/cma.j.issn.1671-0282.2016.08.001 |
| [4] |
王锐, 高永军, 丁凡, 等. 中国2004-2011年毒蕈中毒事件分析[J].
中国公共卫生 , 2014 (2) : 158-161 Wang R, Gao YJ, Ding F, et al. Epidemiological analysis on mushroom poisoning in China 2004-2011[J]. Chin J Public Health , 2014 (2) : 158-161 DOI:10.11847/zgggws2014-30-02-10 |
| [5] | Li P, Deng WQ, Li TH, et al. Illumina-based de novo transcriptome sequencing and analysis of Amanita exitialis basidiocarps[J]. Gene , 2013, 532 (1) : 63-71 DOI:10.1016/j.gene.2013.09.014 |
| [6] | Santi L, Maggioli C, Mastroroberto M, et al. Acute liver failure caused by Amanita phalloides poisoning[J]. Int J Hepatol , 2012, 2012 : 487480 DOI:10.1155/2012/487480 |
| [7] | Vogel G, Tuchweber B, Trost W, et al. Protection by Silibinin against Amanifa phalloides Intoxication in Beagles[J]. Toxicology & Applied Pharmacology , 1984, 73 (3) : 355-362 DOI:10.1016/0041-008X(84)90087-5 |
| [8] | Diaz JH. Syndromic diagnosis and management of confirmed mushroom poisonings[J]. Crit Care Med , 2005, 33 (2) : 427-436 DOI:10.1097/01.CCM.0000153531.69448.49 |
| [9] | Yilmaz A, Gursoy S, Varol O, et al. Emergency room cases of mushroom poisoning[J]. Saudi Med J , 2006, 27 (6) : 858-861 |
| [10] | Berger KJ, Guss DA. Mycotoxins revisited: Part I[J]. Emerg Med J , 2005, 28 (1) : 53-62 DOI:10.1016/j.jemermed.2004.08.013 |
| [11] | Erden A, Esmeray K, Kara H, et al. Acute liver failure caused by mushroom poisoning: a case report and review of the literature[J]. Intl Med Case Rep , 2013, 6 (1) : 85-90 DOI:10.2147/IMCRJ.S53773 |
| [12] |
王鑫, 周丽洁, 桂明杰, 等. 毒菇简易识别、中毒类型及解毒方法[J].
食药用菌 , 2011, 2011 (3) : 58-60 Wang X, Zhou LJ, Gui MJ, et al. Simple identification, poisoning types and detoxification method of poisonous mushroom[J]. Edible and Medicinal Mushrooms , 2011, 2011 (3) : 58-60 |
| [13] |
董国日, 张志光, 陈作红. 鹅膏菌毒素及其毒理研究进展[J].
生物学杂志 , 2000, 17 (2) : 1-3 Dong GR, Zhang ZG, Chen ZH. Amanita toxic peptides and its theory[J]. Jo Biol , 2000, 17 (2) : 1-3 DOI:10.3969/j.issn.2095-1736.2000.03.001 |
| [14] | Jaeger A, Jehl F, Flesch F, et al. Kinetics of amatoxins in human poisoning: therapeutic implications[J]. J Toxicol Clin Toxicol , 1993, 31 (1) : 63-80 DOI:10.3109/15563659309000374 |
| [15] | Vesconi S, Langer M, Iapichino G, et al. Therapy of cytotoxic mushroom intoxication[J]. Criti Care Med , 1985, 13 (5) : 402 DOI:10.1097/00003246-198505000-00007 |
 2016, Vol. 25
2016, Vol. 25




